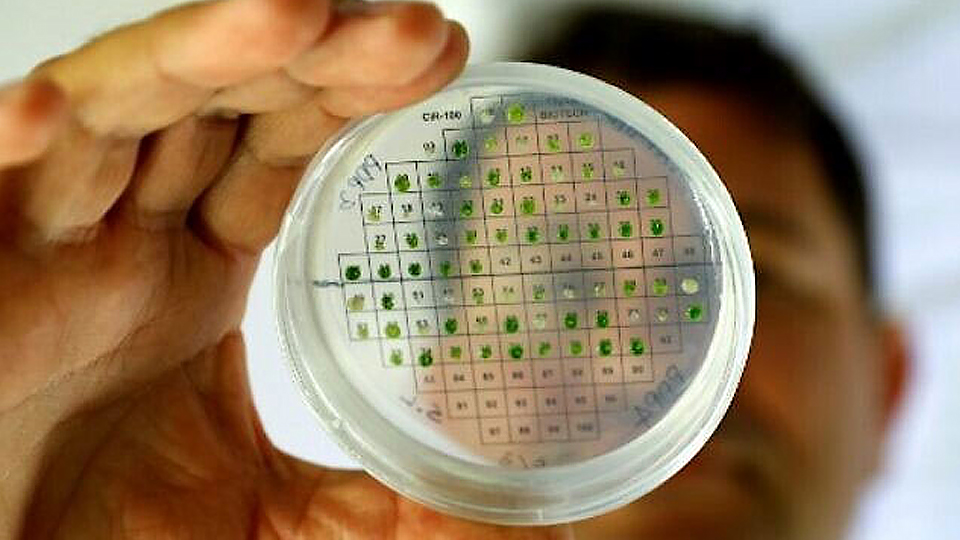
Phát minh vật liệu giúp sản xuất điện trong cơ thể người

C
ác nhà khoa học thuộc trường Đại học Tel Aviv (Israel) đã công bố một loại vật liệu nano có thể “bắt” các bộ phận trong cơ thể sản xuất ra dòng điện.
|
| Nhà khoa học thuộc trường Đại học Tel Aviv kiểm tra các mẫu vi tảo trong quá trình nghiên cứu để chứng minh khả năng tiến hóa của thực vật với mặt trời để tạo ra năng lượng. (Ảnh minh họa: AFP). |
Theo phóng viên tại Tel Aviv, đây là kết quả công trình nghiên cứu do giáo sư Ehud Gazit của trường Shmunis thuộc Đại học Tel Aviv chủ trì. Giáo Gazit cho biết collagen là một protein phổ biến nhất trong cơ thể, có nhiều đặc tính vật lý quan trọng, như tính mềm dẻo và độ bền cơ học. Tuy nhiên, do phân tử collagen lớn và phức tạp, nên từ lâu giới nghiên cứu đã tìm kiếm một phân tử đơn giản hơn nhưng có các đặc tính tương tự. Hơn một năm trước, nhóm nghiên cứu đã sử dụng công nghệ nano để tạo ra một vật liệu đáp ứng các yêu cầu này. Đây là một phân tử rất ngắn, chỉ bao gồm ba axit amin, có khả năng tự lắp ráp để tạo thành cấu trúc xoắn linh hoạt như collagen và khỏe như titan.
Hơn nữa, vật liệu này còn có một đặc tính của collagen đó là khả năng áp điện - tức là có thể tạo ra dòng điện dưới tác dụng của lực cơ học. Ngoài ra, các thí nghiệm còn cho thấy vật liệu này mặc dù có cấu trúc cực nhỏ, chỉ vài trăm nano mét (1 nano mét = 1 phần tỷ mét) nhưng lại có khả năng áp điện cao hơn hẳn các vật liệu áp điện thông thường. Đáng nói là, hầu hết các vật liệu áp điện hiện nay đều chứa chì nên không thích hợp để ứng dụng trong y tế.
Theo các nhà nghiên cứu, loại vật liệu áp điện
mới có ý nghĩa rất lớn. Chúng có thể được dùng để tạo ra động cơ phát điện cung cấp cho các thiết bị siêu nhỏ được cấy trong cơ thể người bệnh, chẳng hạn máy tạo nhịp tim. Nguồn năng lượng duy trì máy phát chính là các chuyển động vật lý của các bộ phận trong cơ thể. Giáo sư Gazit khẳng định: “Nhịp tim, cử động hàm, ruột hoặc bất kỳ chuyển động nào khác diễn ra trong cơ thể một cách thường xuyên – sẽ sạc điện cho thiết bị”.

